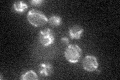
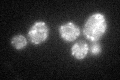

View description
Ribose methyltransferase that modifies a functionally critical, conserved nucleotide in mitochondrial 21S rRNA
Localization:
Intensity:
Fold change:
Significance:
-
C’ GFP library in SD
mitochondria27.7 -
N' NOP1pr-GFP in SD

mitochondria59.3993 -
N' TEF2pr-mCherry in SD

mitochondria42.1591 -
N' NATIVEpr-GFP in SD

mitochondria91.2531 -
N' TEF2pr-VC and Cyto-VN in SD

#N/A0 -
C’ GFP library in SD+DTT
mitochondria24.850.89No -
C’ GFP library in SD+H2O2

mitochondria24.610.88No -
C’ GFP library in Starvation Media

mitochondria22.650.81No -
C’ GFP library on the background of Pup2-DaMP

mitochondria -
C’ GFP library on the background of CCT mutant

mitochondria29.39341.061No
